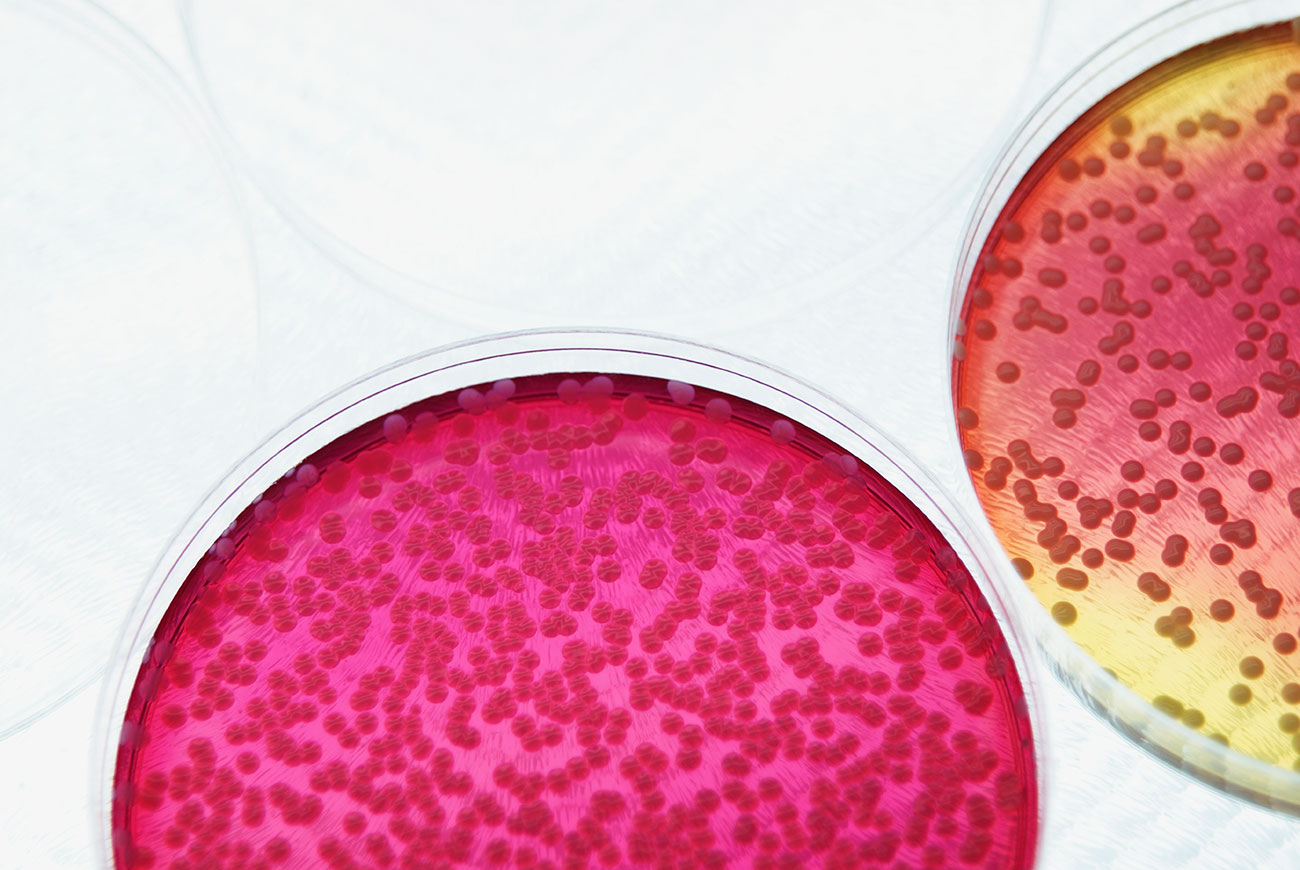

Are you interested in performing original biological research at CSN?
Phone: +1 702 651 4569
Office: S221A, North Las Vegas Campus
Hours: Mon/Wed: 8:30 - 9:30 a.m.
Tue/Thu: 11:30 - 12:30 a.m.

Are you interested in performing original biological research at CSN?
Phone: +1 702 651 4569
Office: S221A, North Las Vegas Campus
Hours: Mon/Wed: 8:30 - 9:30 a.m.
Tue/Thu: 11:30 - 12:30 a.m.